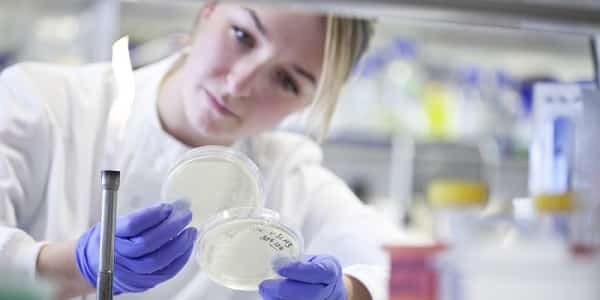

National Institute of Cancer Prevention & Research – ICMR, Inviting Applications For PhD Program – 2016
NATIONAL INSTITUTE OF CANCER PREVENTIVE AND RESEARCH,
(Formerly ICPO), ICMR I-7, Sector 39, Noida, 201301
ADMISSION TO Ph.D. PROGRAM-2016
National Institute of Cancer Prevention and Research (Formerly ICPO), ICMR invites applications from bright young individuals from diverse backgrounds with strong motivation and good academic credentials to pursue research in frontier areas of modern biology leading to a Ph.D. degree.
The broad interdisciplinary research areas are Cancer Biology, Cancer Genetics, Vaccine, Infectious Diseases, Bioinformatics, Drug Designing, Cytopathology, Community Medicine & Preventive Oncology.
WHO CAN APPLY : Masters’ degree (M.Sc./M.Tech.) with 60% (or equivalent in CGPA) in any branch of Life Science or Bioinformatics or Biostatistics or having a medical qualification (MBBS/ MD/MS/DM/M.Ch) and preferably holding fellowship such as CSIR-UGC(JRF)/ICMR-JRF/DBT-JRF/DST-INSPIRE/ (fellowship certificate should be valid at the time of admission).
Age Limit: Upper age limit is 30 years, relaxable for SC/ST/OBC/physically handicapped persons as well as woman candidates as per Govt. of India rules.
HOW TO APPLY: A downloadable link to the application form is available at http://bic.icmr.org.in/icpo/documents/vacancy/Application_form_NICPR_Ph.D._Pr ogram_2016.pdf
Applications, complete in all respect, should reach Director, National Institute of Cancer Prevention and Research (Formerly ICPO), ICMR, NOIDA on or before May 20, 2016.
SELECTION PROCEDURE : Candidates fulfilling minimum requirements will be invited through email to appear for an Interview. The date and time of the interview will be declared on Institute’s website (http://icpo.org.in). Individual letters regarding date and time of interview will not be sent. NICPR reserves the right to change the minimum eligibility requirements in case of receipt of large number of applications. The decision of the Director, NICPR will be final and no correspondence will be entertained in this regard. No TA/DA will be paid at any stage of the selection process.
The decision of the Admission Committee will be final and binding and no correspondence will be entertained in this regard. Canvassing in any form and/or bringing in any influence will be treated as a disqualification. In case of eligible candidates with already activated JRF fellowships, the consent letter from appropriate authority is to be submitted to NICPR, NOIDA at the time of interview otherwise the candidature is liable to cancellation. Candidates should note that non-fulfillment of the eligibility criterion will result in cancellation of candidature at any stage of admission process.
Last date for submission of the application: May 20, 2016
Important: Filled in application (hard copy) along with self attested copies of certificates should reach Director, National Institute of Cancer Prevention and Research, (Formerly ICPO), ICMR, I-7, Sector 39, Noida, 201301, India on or before closing date i.e. May 20, 2016. Envelope should be marked as “NICPR Ph.D. Program 2016”. The Institute shall not be liable for non-receipt of the application due to postal delay/ loss.